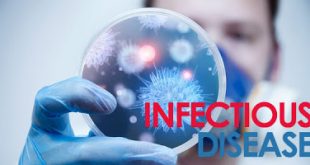

της Κλεοπάτρας Ζουμπουρλή, μοριακή βιολόγος, medlabnews.gr ΤΣΙΜΠΟΥΡΙΑ Πολλά έντομα μας δημιουργούν προβλήματα και ενοχλητικά τσιμπήματα, όπως οι μέλισσες, οι ψείρες και οι αράχνες. Λίγα όμως μπορούν να κρυφτούν κάτω από το δέρμα μας όπως τα τσιμπούρια. Εάν σαν αρέσουν οι βόλτες στην εξοχή πρέπει να είστε πολύ προσεκτικοί καθώς τα τσιμπούρια …
ΠερισσότεραΈνας πονόλαιμος μπορεί να οφείλεται σε αμυγδαλίτιδα. Πώς θα το καταλάβουμε και πώς αντιμετωπίζεται;
του Κωνσταντίνου Λούβρου, M.D., medlabnews.gr Ο πόνος στο λαιμό είναι σύμπτωμα πολλών παθήσεων. Συνήθως, ο πονόλαιμος οφείλεται σε ιογενείς φλεγμονές που προκαλούν τη γρίπη ή το κρυολόγημα. Η αμυγδαλίτιδα είναι από τις συνηθέστερες αιτίες πονόλαιμου. Η αμυγδαλίτιδα είναι η φλεγμονή των παρίσθμιων αμυγδαλών που οφείλεται σε μικρόβια ή ιούς. Είναι …
ΠερισσότεραΠότε κάνουμε την γενική ούρων και τι δείχνει; Πώς πρέπει να γίνει η συλλογή και τι προετοιμασία χρειάζεται;
της Αγγελικής Μήλιου, βιολόγος, medlabnews.gr Το ουροποιητικό σύστημα είναι ανοικτό στο περιβάλλον. Παρά την επαφή του με το εξωτερικό περιβάλλον, και εκτός από τελικό τμήμα της ουρήθρας, σε φυσιολογική κατάσταση , είναι στείρο. Οι λοιμώξεις του ουροποιητικού συστήματος είναι αρκετά συχνές. Τα ούρα επιμολύνονται εύκολα κατά την έξοδό τους από …
ΠερισσότεραΛιμός απειλεί 6,5 εκατ. παιδιά στο Κέρας της Αφρικής
Με λιμό, υποσιτισμό και θάνατο απειλούνται 6,5 εκατομμύρια παιδιά στο Κέρας της Αφρικής, στις πάμφτωχες, άνυδρες περιοχές της Σομαλίας, της Αιθιοπίας και της Κένυας λόγω των αλλεπάλληλων περιόδων ανομβρίας, προειδοποίησε σήμερα μια φιλανθρωπική οργάνωση, καθώς και οι ανοιξιάτικες βροχές προβλέπεται ότι θα είναι λιγοστές. Η συνεχιζόμενη ξηρασία έχει βυθίσει στην …
ΠερισσότεραΔημιουργήθηκαν από ‘Ελληνα επιστήμονα στις ΗΠΑ κουνούπια ανθεκτικά στον ιό του δάγκειου πυρετού
Ερευνητές στις ΗΠΑ, με επικεφαλής έναν Έλληνα επιστήμονα της διασποράς, δημιούργησαν κουνούπια που είναι ανθεκτικά στον ιό του δάγκειου πυρετού. Το επίτευγμα αυτό, που κατέστη εφικτό χάρη στην κατάλληλη γενετική τροποποίηση των κουνουπιών, μπορεί να βοηθήσει μελλοντικά στον περιορισμό της εξάπλωσης της νόσου διεθνώς. Ο ιός του δάγκειου προσβάλλει κάθε …
ΠερισσότεραΟυρολοίμωξη στα παιδιά; Κυστίτιδα, πυελονεφρίτιδα. Τι πρέπει να προσέξετε;
των Αλέξανδρου Γιατζίδη M.D. και Κωνσταντίνου Λούβρου, M.D., medlabnews.gr Η ουρολοίμωξη είναι η μόλυνση με μικρόβια του ουροποιητικού συστήματος του ανθρώπου (ουρήθρα, ουροδόχος κύστη, ουρητήρες και οι νεφροί). Η έκφραση ουρολοίμωξη είναι ένας γενικότερος όρος που αγκαλιάζει ένα ευρύτερο πεδίο. Ουσιαστικά μιλάμε για την λοίμωξη του ουροποιητικού. Υπάρχουν σοβαρές διαφορές …
ΠερισσότεραΒαρύτατο το κόστος σε ανθρώπινες ζωές από ενδονοσοκομειακές λοιμώξεις στη χώρα μας
Επιδημία διαρκείας με βαρύτατο κόστος σε ανθρώπινες ζωές χαρακτηρίζονται οι ενδονοσοκομειακές λοιμώξεις στη χώρα μας, αφού κάθε χρόνο τουλάχιστον 1.000 θάνατοι σχετίζονται με ενδονοσοκομειακές βακτηριαιμίες που έχουν προκληθεί από πολυανθεκτικά μικρόβια, σύμφωνα με ρεπορτάζ της “Καθημερινής της Κυριακής”. Σύμφωνα με την τελευταία εθνική καταγραφή του ΚΕΕΛΠΝΟ, το 9% των ασθενών …
ΠερισσότεραΚατάλληλες τροφές για την γρίπη, τις ιώσεις, πλούσιες σε βιταμίνες, μέταλλα, αντιοξειδωτικά
της Κλεοπάτρας Ζουμπουρλή, μοριακή βιολόγος, medlabnews.gr Αυτή την εποχή είναι σε έξαρση πολλές ιώσεις. Οι απότομες αλλαγές του καιρού έχουν ως αποτέλεσμα πολλοί από εμάς να ταλαιπωρούμαστε από συνάχι και βήχα. Ο οργανισμός μας πρέπει να είναι πλήρως καλυμμένος με βιταμίνες, μέταλλα, ιχνοστοιχεία και όλα τα απαραίτητα θρεπτικά συστατικά, ώστε να …
ΠερισσότεραΚυκλοφορεί γαστρεντερίτιδα. Ποια τα συμπτώματα και πώς αντιμετωπίζεται;
του Αλέξανδρου Γιατζίδη, M.D., medlabnews.gr Τα κρούσματα γαστρεντερίτιδας παίρνουν διαστάσεις επιδημίας. Η γαστρεντερίτιδα αποτελεί τη δεύτερη πιο συχνή ίωση μετά το κοινό κρυολόγημα, επειδή μεταδίδεται πολύ εύκολα. Τα βαριά για την εποχή φαγητά, τα λαχανικά, αλλά και η κακή συντήρηση μπορούν να οδηγήσουν σε αλλοιώσεις των τροφών, με δυσάρεστες συνέπειες για την …
ΠερισσότεραΜε ποιους τρόπους μεταδίδεται η HIV λοίμωξη και πώς μεταδίδεται κάνοντας σεξ χωρίς προφυλάξεις;
του Αλέξανδρου Γιατζίδη, M.D., medlabnews.gr ανανεώθηκε στις 30/11/2016 Πως μεταδίδεται η HIV λοίμωξη; Ο HIV είναι ένας ιός. Μερικοί ιοί, όπως αυτοί που προκαλούν το κοινό κρυολόγημα ή την γρίπη, παραμένουν στο σώμα μόνο για μερικές μέρες. Μερικοί ιοί, όπως ο HIV, δεν φεύγουν ποτέ. Ο ιός του AIDS είναι …
ΠερισσότεραΤι είναι ο λοιμωξιολόγος και τι η λοιμωξιολογία; Σε ποιες παθήσεις επεμβαίνει. Μονάδες Λοιμώξεων
του Κωνσταντίνου Λούβρου, M.D., medlabnews.gr Η Λοιμωξιολογία αποτελεί επίσημη και αναγνωρισμένη εξειδίκευση της Παθολογίας και της Παιδιατρικής. Οι περισσότερες κοινές λοιμώξεις μπορούν να αντιμετωπιστούν με επιτυχία από τον προσωπικό σας ιατρό . Ωστόσο ο γιατρός σας, μπορεί χρειαστεί να σας παραπέμψει σε έναν ειδικό όταν • μια λοίμωξη είναι δύσκολο …
ΠερισσότεραΣυμπτώματα που προειδοποιούν για διαβήτη (video)
της Αγγελικής Μήλιου, βιολόγος, medlabnews.gr Κάθε 10 δευτερόλεπτα 4 άνθρωποι εμφανίζονται με διαβήτη και ταυτόχρονα άλλα 2 μένουν αδιάγνωστα. Ο Σακχαρώδης Διαβήτης μπορεί να εμφανιστεί στον καθένα ανεξάρτητα από την ηλικία, το χρώμα ή το φύλο. Είναι μια χρόνια νόσος που όταν δεν είναι σωστά ρυθμισμένη μπορεί να φέρει απειλητικές για …
ΠερισσότεραΚίνδυνος λοίμωξης σε ασθενείς με κυστική ίνωση
Σε όλο τον κόσμο έχει εξαπλωθεί μια -ανθεκτική σε πολλά φάρμακα- λοίμωξη από ένα μυκοβακτήριο, που μπορεί να εξαπλωθεί από ασθενή σε ασθενή με κυστική ίνωση και να απειλήσει τη ζωή του. Τον κώδωνα κρούουν Βρετανοί και άλλοι επιστήμονες, σύμφωνα με τους οποίους η λοίμωξη γίνεται όλο και πιο συχνή. …
Περισσότερα9ο Πανελλήνιο Συνέδριο Ελέγχου Λοιμώξεων 2-4 Νοεμβρίου 2016, Αθήνα
«Ο Έλεγχος των Λοιμώξεων είναι η μόνη δυνατή λύση» ΕΛΛΗΝΙΚΗ ΕΤΑΙΡΕΙΑ ΕΛΕΓΧΟΥ ΛΟΙΜΩΞΕΩΝ (ΕΕΕΛ) Μείζον θέμα υγείας σε εθνικό και διεθνές επίπεδο αποτελεί ο έλεγχος των λοιμώξεων, ο οποίος αφορά το σύνολο του ιατρικού, νοσηλευτικού και παραϊατρικού προσωπικού όλων των βαθμίδων, καθώς και όλους όσοι ασχολούνται με οποιονδήποτε τρόπο με …
ΠερισσότεραΚέντρο Ζωής: Επιστολή προς Υπ. Υγείας σχετικά με το πρόβλημα της έλλειψης αντιδραστηρίων
Απευθυνόμαστε σε εσάς ως Σωματείο για την υποστήριξη των ανθρώπων που ζουν με HIV/AIDS στην Ελλάδα, υπερασπιζόμενο τα δικαιώματα και τα έννομα συμφέροντά τους. Το πρόβλημα της έλλειψης αντιδραστηρίων για τη διενέργεια ανοσολογικού ελέγχου σε οροθετικούς ασθενείς ολοένα και διογκώνεται. Το Κέντρο Ζωής γίνεται δέκτης καταγγελιών από οροθετικούς ασθενείς, οι …
Περισσότερα Ιατρικά Νέα Θέματα για την υγεία | Το εγκυρότερο ελληνικό portal με θέματα υγείας, διατροφής, ομορφιάς, φυσικής κατάστασης, ιατρικών θεμάτων
Ιατρικά Νέα Θέματα για την υγεία | Το εγκυρότερο ελληνικό portal με θέματα υγείας, διατροφής, ομορφιάς, φυσικής κατάστασης, ιατρικών θεμάτων